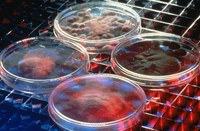
Fighting cancer with viruses

Among the strategies devised to combat tumors over the past 15 years, the transfer of therapeutic genes into cells where original genes are malfunctioning – an approach called gene therapy – continues to holds promise. However, experts note that a number of challenges need to be resolved before gene therapy can be adopted as a routine form of medical treatment.
Among the strategies devised to combat tumors over the past 15 years, the transfer of therapeutic genes into cells where original genes are malfunctioning – an approach called gene therapy – continues to holds promise. However, experts note that a number of challenges need to be resolved before gene therapy can be adopted as a routine form of medical treatment.
Liu Xin-Yuan ( TWAS Fellow 2000), professor and head of the Cancer Laboratory at the Shanghai Institute of Biochemistry and Cell Biology (SIBCB), is one of China's pioneers of gene therapy. With a background in chemistry and broad experience in molecular biology, Liu first gained international acclaim for his research on interferons – proteins that white blood cells produce in response to viruses, bacteria, parasites and tumors. He has drawn upon the knowledge and insights he gained in studying interferons to conduct cutting-edge research on gene therapy.
TWAS Fellow 2000), professor and head of the Cancer Laboratory at the Shanghai Institute of Biochemistry and Cell Biology (SIBCB), is one of China's pioneers of gene therapy. With a background in chemistry and broad experience in molecular biology, Liu first gained international acclaim for his research on interferons – proteins that white blood cells produce in response to viruses, bacteria, parasites and tumors. He has drawn upon the knowledge and insights he gained in studying interferons to conduct cutting-edge research on gene therapy.
Liu, who has authored some 380 papers and received more than 40 awards, including the prestigious Hong Kong He Liang prize, explains: "Over the past decade, my team and I have been exploring the so-called Gene Armed Oncolytic Virus Therapy (GAOVT), which calls for arming viruses with a gene that only harms the tumor cells".
"Physiologically," Liu says, "viruses do not discriminate among the cells they infect. Once inside the cells, they destroy the host by producing thousands of viral copies that ultimately overwhelm the healthy cells." Each cycle of replication produces an enormous number of infectious particles that diffuse throughout the organism.
"But viruses can be 'domesticated' or, at least, induced to act in a more discriminatory way," Liu notes. Based on that notion, Liu and his team modified the DNA of a specific family of viruses, called adenoviruses, so that they would only recognize and enter tumor cells.
They also armed the viruses with two weapons. The first, a gene called TRAIL, exerts strong anti-tumor activity in many tumor models by stimulating a process called apoptosis, or cell suicide. While providing a useful defense against the growth of cancers, resistance to TRAIL has become increasingly commonplace among patients. For this reason, Liu and co-workers turned to a second weapon, a gene called hSSTr2 that sensitizes cells to TRAILS' anti-tumor actions. Think of hSSTr2 as a booster agent.
"By using this approach," Liu observes, "we are trying to contain pancreatic and liver cancers. Both are particularly aggressive cancers that pose dire health threats to patients as well as compelling challenges to researchers and doctors." Pancreatic cancer, in particular, is not only aggressive but also highly resistant to treatment. Nearly half of the patients who develop the disease die within 6 months and less than 5% are alive 5 years after the initial diagnosis.
"TRAIL exhibits a high specificity for tumor cells," Liu points out, "activating a cascade of chemical reactions that ultimately leads to the death of malignant cells. Its gene partner, hSSTr2, helps spur the process when TRAIL fails to act."
Liu's approach has also opened up additional avenues of research, including the potential to apply the therapy to micro-metastases that arise far from the primary tumor.
"We are still in the early stages of our research and clinical investigations," says Liu. "But the results so far are promising and we plan to continue exploring ways to encourage viruses to inflict harm solely on the cancerous cells that are doing us harm."

